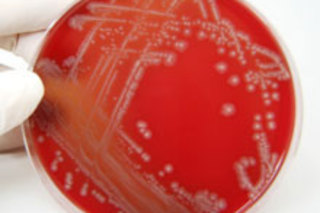

显微镜的发明让科学家们得以观察到最微小的细胞。现在,想象一下这样一种设备,它不仅可以观察微小的细胞,还可以倾听它们的活动。一个科学家团队正在建造一个“微型耳朵”,它利用微小的珠子和激光来放大和测量分子尺度的振动。该团队希望这种新设备很快能成为标准的实验室设备,让科学家们能够
倾听细菌(如大肠杆菌)以及引起睡眠病等疾病的微生物的运动 [The Daily Beast]。
微型耳朵基于一种成熟的技术,该技术使用激光来测量微小的力。“光镊”
通过将非常小的玻璃或塑料珠子悬浮在激光束中工作。测量这些珠子在受到微小物体撞击时的运动,可以测量分子尺度上发生的微小力 [BBC]。
光镊非常敏感,可以测量皮牛顿级的力,这相当于
一粒盐静置在桌面上所施加的力的百万分之一 [BBC]。
但与光镊(单个激光束测量微小物体施加的力)不同,微型耳朵将使用一圈带有珠子的激光束来倾听所研究的物体。科学家们说,这一圈激光束可以拾取细菌利用鞭毛向前运动时产生的运动。这种运动会导致带电珠环产生不同程度的摆动,所有这些摆动都使用高速相机进行测量。然后将该输出连接到扬声器,以便研究人员可以听到细菌的振动。该设备已经拾取了布朗运动,让研究人员能够倾听原子和分子在液体中晃动。新的微型耳朵还可以帮助科学家了解有害细菌如何移动,以及如何使用药物阻止它们的运动。
在Facebook上加入Discover MagazineFacebook
. 相关内容:80beats: 一角硬币大小的显微镜可能成为发展中国家健康的福音 80beats:显微镜-手机组合可以发现发展中国家的疾病 80beats: 新的纳米级成像技术拍摄病毒的3D图像 DISCOVER: 世界上最小的秤可以称量单个分子图片来源:iStockphoto